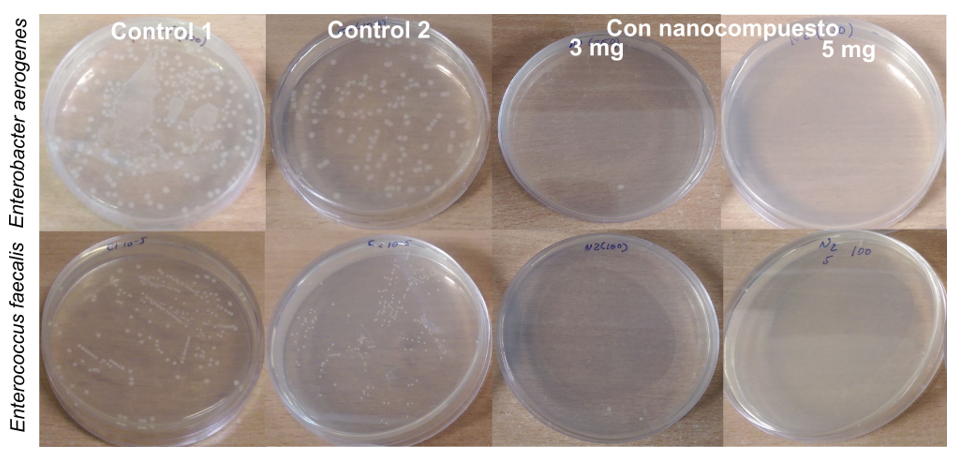
Placas
despu&eacute;s de la incubaci&oacute;n a 37&deg;C para el Control 1, Control 2 y tratamiento con
el nanocompuesto de las bacterias Enterobacter aerogenes y Enterococcus faecalis.

Fisicoquímica e Inorgánica
Síntesis y caracterización de nanocompuestos Fe3O4/Ag: su efecto contra Enterobacter aerogenes y Enterococcus faecalis
Synthesis and characterization of nanocompounds Fe3O4/Ag: its effect against Enterobacter aerogenes and Enterococcus faecalis
Síntese e caracterização de nanocompósitos Fe3O4/Ag: seu efeito contra Enterobacter aerogenes e Enterococcus faecalis
Síntesis y caracterización de nanocompuestos Fe3O4/Ag: su efecto contra Enterobacter aerogenes y Enterococcus faecalis
Revista Colombiana de Química, vol. 48, núm. 2, pp. 33-39, 2019
Universidad Nacional de Colombia
Recepción: 30 Julio 2018
Aprobación: 19 Febrero 2019
Resumen: En el presente trabajo, se reporta la síntesis y caracterización de nanopartículas magnéticas de magnetita/plata (Fe3O4/Ag) para el estudio de sus propiedades antibacterianas frente a las bacterias Enterobacter aerogenes (Gram-negativa) y Enterococcus faecalis (Gram-positiva). Las nanopartículas magnéticas de magnetita (MNPs) se sintetizaron por el método de sol-gel, usando bromuro de cetiltrimetilamonio (CTAB) como surfactante. Posteriormente, en la dispersión coloidal de magnetita, se llevó a cabo la reducción química in situ de iones de plata, usando glucosa como agente reductor y polivinilpirrolidona (PVP) como agente dispersante, para obtener un nanocompuesto magnético Fe3O4/Ag. El análisis morfológico y espectroscópico de las nanopartículas de Fe3O4 y del nanocompuesto de Fe3O4/Ag fue realizado mediante la espectroscopia infrarroja con transformada de Fourier (FTIR), Raman, y Mössbauer (MS), además de la técnica de difracción de rayos X (DRX), la microscopía electrónica de barrido (SEM) y espectroscopia de energía dispersiva de rayos X (EDS). Las nanopartículas de Fe3O4 resultaron esféricas con un diámetro medio de 10 nm y el nanocompuesto de Fe3O4/Ag con un tamaño medio de 28 nm, el Test antibacteriano indicó que el uso del nanocompuesto de Fe3O4/Ag a una concentración de 5 mg·mL-1 permite una inhibición total del crecimiento de los microorganismos estudiados a partir de una concentración inicial 108 bacterias mL-1.
Palabras clave: nanocompuesto de Fe3O4/Ag, magnético, sol–gel, actividad antibacteriana.
Abstract: In the present study, we report the synthesis and characterization of magnetite/silver magnetic nanoparticles (Fe3O4/Ag) and the study of their antibacterial properties against the bacteria Enterobacter aerogenes (Gram-negative) and Enterococcus faecalis (Gram-positive). Magnetite magnetic nanoparticles (MNPs) were prepared by a sol-gel method using cetyltrimethylammonium bromide (CTAB), as a surfactant, followed by in-situ chemical reduction of silver ions by glucose, and polyvinylpyrrolidone (PVP), as a dispersive agent, to obtain the antibacterial nanocomposite of Fe3O4/Ag. Morphological and spectroscopic studies of magnetite nanoparticles and nanocomposite were carried out using the Fourier transform infrared spectroscopy (FTIR), Raman spectroscopy, Mössbauer spectroscopy (MS), X-ray diffraction (XRD), scanning electron microscopy (SEM), and energy dispersive X-ray spectroscopy (EDS). Spherical Fe3O4 MNPs showed an average diameter of 10 nm and the average size for nanocomposite was 28 nm. The antibacterial test indicated that the use of the nanocomposite of Fe3O4/Ag at a concentration of 5 mg·mL-1 allowed a total inhibition of the growth of the microorganisms studied from an initial concentration of 108 bacteria mL-1.
Keywords: Fe3O4/Ag nanocomposite, magnetic, sol – gel, antibacterial activity.
Resumo: No presente trabalho, relatamos a síntese e caracterização de nanopartículas magnéticas de magnetita/ prata (Fe3O4/Ag) e o estudo de suas propriedades antibacterianas contra as bactérias Enterobacter aerogenes (Gram-negativo) e Enterococcus faecalis (Gram-positivas). Nanopartículas magnéticas de magnetita (MNPs) foram sintetizadas pelo método sol-gel usando o bromuro de cetiltrimetilamonio (CTAB) como surfactante. Posteriormente, na dispersão coloidal de magnetita, a redução química in situ dos íons de prata foi realizada utilizando-se glicose, como agente redutor, e polivinilpirrolidona (PVP), como agente dispersante, para obter um nanocompósito magnético Fe3O4/Ag. A análise morfológica e espectroscópica das nanopartículas de Fe3O4 e do nanocompuesto de Fe3O4/Ag conduziu-se através da espectroscopia infravermelha com transformada de Fourier (FTIR), Raman, e Mössbauer (MS), además da técnica de raio X da deformação (DRX), a microscopia eletrônica de barrido (SEM) e a espectroscopia de energia dispersiva de raios X (EDS). As nanopartículas de Fe3O4 têm formas esféricas com um diâmetro médio de 10 nm e o nanocompósito de Fe3O4/Ag com um tamanho promédio de 28 nm. O teste antibacteriano indicou que o uso do nanocompósito Fe3O4/Ag na concentração de 5 mg·mL-1 permitiu inibir totalmente o crescimento dos microrganismos estudados a partir de uma concentração inicial de 108 bactérias mL-1.
Palavras-chave: nanocompósito de Fe3O4/Ag, magnético , sol-gel, atividade antibacteriana.
Introducción
Los agentes antibacterianos son necesarios para evitar las enfermedades infecciosas causadas por bacterias patógenas. Entre los agentes antibacterianos potencialmente activos se encuentran la plata y otros óxidos metálicos tales como el TiO2 y el ZnO [1]. La plata tiene propiedades inherentes tales como alta estabilidad térmica, durabilidad, buen rendimiento antibacteriano, baja toxicidad a cierta concentración para las células, versatilidad y buena actividad a largo plazo [2]. A pesar de esto, las nanopartículas de Ag no pueden reciclarse para ser reutilizadas en el tratamiento de aguas residuales e incluso una alta concentración de estas en el agua puede ser un riesgo potencial para la salud [3]. Así pues, el nivel máximo de contaminación con plata en el agua potable (establecido para evitar la acumulación de plata en el cuerpo humano), según la Organización Mundial de la Salud (WHO), es de 100 ppb [4]. Una de las alternativas para mejorar su uso es obtenerla en una matriz específica, por ejemplo, matrices magnéticas, ya que el uso de un campo magnético externo permitiría mejorar los procesos de separación y reutilización de las nanopartículas de plata en el tratamiento de aguas contaminadas [5].
Para aplicaciones de tratamiento de agua y biomedicina, las partículas magnéticas (MNPs) deben ser dispersables en un medio acuoso, ser químicamente estables, biocompatibles y poseer sitios activos en su superficie [6]. En este sentido, entre los trabajos reportados, Vergés [7] propone un método para la obtención de nanopartículas de magnetita a partir de la oxidación de una sal de hierro (II) (FeSO4) en medio básico, con tamaños de alrededor de 30-60 nm.
Por otra parte, se han documentado rutas de síntesis para los nanocompuestos de Fe3O4/Ag [1], tales como el expuesto por Ivashchenko [8], el cual presenta la síntesis del nanocompuesto de magnetita/plata/antibiótico para terapia antimicrobiana. Por su parte, Amarjargal [9] propone la síntesis del nanocompuesto de Fe3O4/Ag por método hidrotermal. Otros trabajos aplicativos mencionan el uso de nanopartículas core-shell de óxido de hierro/plata en tratamientos antibacterianos [6], [10-13], donde las bacterias estudiadas en su mayoría son Escherichia coli, Pseudomonas, Staphylococcus aureus y Bacillus subtilis.
En esta investigación se presenta la síntesis del nanocompuesto de magnetita/plata (Fe3O4/Ag), a partir de la reducción química in situ de iones plata sobre la dispersión coloidal de magnetita, donde la glucosa actúa como agente reductor y el PVP como agente dispersante.
En cuanto a las bacterias estudiadas en esta investigación, la bacteria Gram negativa Enterobacter aerogenes pertenece al grupo de Coliformes Totales que son indicadores de contaminación en aguas, de acuerdo con la Norma Técnica Nacional (NTN ITINTEC 214.003 - Perú). Esta bacteria coloniza las superficies interiores de las tuberías de agua y los tanques de almacenamiento y crece hasta convertirse en una biopelícula cuando las condiciones son favorables [14].
Por otra parte, la bacteria Gram positiva Enterococcus faecalis es uno de los indicadores bacteriológicos más eficientes para evaluar la calidad del agua de mar, ya que es muy resistente a las condiciones de este medio y está directamente relacionada con gastroenteritis, enfermedades respiratorias, conjuntivitis, dermatitis, entre otros [15]. En el agua de pozo, esta bacteria puede producir gastroenteritis humana, y existe una relación directa entre su densidad y la aparición de enfermedades entéricas, por ello es utilizada como indicador de contaminación fecal cuando son comparados con los coliformes [16].
Por lo anterior, en la presente investigación se estudia la actividad antimicrobiana del nanocompuesto de Fe3O4/Ag, sintetizado a partir de un recubrimiento de Ag sobre nanopartículas magnéticas de magnetita (MNPs de Fe3O4) frente a las bacterias Enterobacter aerogenes y Enterococcus faecalis, para que posteriormente puedan aplicarse a tratamientos de aguas contaminadas, mejorando así la calidad del agua y evitando las enfermedades mencionadas.
Materiales y métodos
Reactivos
Cloruro de hierro (II) tetrahidratado (FeCl2.4H2O), hidróxido de sodio y nitrato de sodio (Merck, Alemania). Citrato de sodio (Sigma Aldrich, USA), bromuro de hexadeciltrimetilamonio, CTAB (Sigma Aldrich, USA), nitrato de plata (Merck, Alemania), polivinilpirrolidona, PVP (Sigma Aldrich, USA), glucosa (Merck, Alemania). Todos los reactivos fueron de grado analítico. Dos cepas bacterianas de referencia, Enterobacter aerogenes (ATCC® 13048TM) y Enterococcus faecalis (ATCC® 29212 TM) de American Type Culture Collection (ATTC, USA). Cloruro de sodio 9% (BiBraun, Perú) y caldo CM1135 Brain Heart Infusion (BHI) de OXOID, Inglaterra.
Síntesis de nanopartículas de magnetita (MNPs de Fe3O4)
El método sol-gel para la síntesis de las MNPs de Fe3O4 fue modificado por la adición del surfactante CTAB, con la intención de llevar un control electrostático de los soles [7]. Para esto, se añadieron gota a gota, en paralelo, una solución de FeCl2·4H2O 5,0 x 10-2 mol·L-1 y una de NaOH 0,8 mol·L-1 sobre una mezcla de citrato de sodio 0,05 mol·L-1 y nitrato de sodio NaNO3 0,2 mol·L-1.
El agente surfactante, CTAB (0,1% p/v), se usó para proporcionar repulsión electrostática y evitar la agregación de las nanopartículas. La dispersión inorgánica se agitó durante 1 h en un sistema cerrado y se mantuvo a 80 ºC con una chaqueta de calentamiento en un baño de agua con recirculación y flujo de nitrógeno. Para la caracterización, las MNPs de Fe3O4 se separaron usando un imán y se lavaron cinco veces con agua ultrapura. El producto final se secó en estufa a 70 °C durante 8 h.
Síntesis del nanocompuesto de magnetita/plata (Fe3O4/Ag)
Una solución de AgNO3 5,0 x 10-3 mol·L-1 fue agregada gota a gota sobre una dispersión coloidal de MNPs de magnetita, considerando el rango reportado entre 10-3 y 10-2 mol·L-1 [6, 9, 10]. La glucosa a una concentración de 0,08 mol·L-1 y el PVP (0,3 % p/v) se usaron como agente reductor y dispersante respectivamente. El pH de la suspensión coloidal del nanocompuesto fue de 11,5. Seguidamente, los sólidos del nanocompuesto de Fe3O4/Ag se separaron usando un imán y se lavaron cinco veces con agua ultrapura. Finalmente, la muestra se secó a 70 °C durante 8 h. Las posibles reacciones durante la síntesis son las siguientes: el ion plata Ag+ forma un complejo con el PVP, reacción (1):
(1)Luego, ocurre una reacción redox entre el complejo Ag(PVP)+ y la glucosa. El complejo Ag(PVP)+ se reduce a Ag(PVP) y la glucosa se oxida a ácido glucónico en medio básico, según las reacciones (2) y (3):
(2)
(3)La formación del ácido glucónico ocurre mediante un mecanismo de adición nucleofílica entre el ion hidroxilo y la glucosa. Reacción (4):
(4)El mecanismo de protección del PVP sobre las partículas de plata puede ser planteado con base en las investigaciones de Wang et al. [17] y Banerjee et al. [18], según las reacciones (5) y (6). En la reacción (5) el ion plata Ag+ interactúa con el N y con el O del grupo carbonilo en el PVP. Luego, este ion se reduce al oxidarse la glucosa hasta el ácido glucónico. El producto final es la plata en interacción con el N y el O del grupo carbonilo del PVP, reacción 6, resultando un efecto estabilizador al crear una capa protectora sobre las partículas, lo cual evita su crecimiento y aglomeración.
(5)
(6)Propiedad antibacteriana del nanocompuesto de magnetita/plata (Fe3O4/Ag)
Se investigó el efecto del nanocompuesto frente a bacterias Gram negativas y Gram positivas, usando un método estándar modificado ASTM (método de prueba estándar E2149-01 para determinar la actividad de agentes antimicrobianos inmovilizados bajo condiciones de contacto dinámico) [6]. Todos los materiales fueron esterilizados a 121 °C por 15 min en una autoclave marca Winters. Las colonias de Enterobacter aerogenes (ATCC® 13048TM) y Enterococcus faecalis (ATCC® 29212TM) se sembraron en una placa de Petri y luego, se inocularon en un tubo con 5 mL de caldo Brain Heart Infusion (BHI) [6], con los respectivos controles de esterilidad. Los cultivos se incubaron a 37 °C durante aproximadamente 3 h, hasta alcanzar la densidad óptica (D.O) de 0,5 en la escala de MacFarland que corresponde a una concentración de 108 unidades formadoras de colonias por mL (UFC mL-1). Las pruebas antibacterianas se realizaron en una cabina de flujo laminar clase I marca Nuaire, previamente todos los materiales se irradiaron con luz UV por 15 min. La suspensión bacteriana se diluyó en serie con solución salina normal al 9% y en relaciones v/v de 10-2, 10-3, 10-4 y 10-5. Se llevaron a cabo dos controles (sin nanocompuesto), uno sin agitación y a temperatura ambiente y el otro con agitación y a temperatura de 37 °C. Las placas se incubaron durante 24 h a 37 °C (Enterobacter aerogenes) y durante 48 h a 37 °C (Enterecoccus faecalis) para determinar el número de colonias crecidas expresadas en unidades formadoras de colonias (UFC). El nanocompuesto de Fe3O4/Ag (5 mg) se agitó en 1 mL de una suspensión bacteriana que contenía cada una de las bacterias estudiadas durante 50 min [6] a 37 °C. El sobrenadante se separó del nanocompuesto, utilizando un imán de neodimio, y se colocó en placas de agar sin diluciones. Estas placas se incubaron durante 24 h a 37 °C (Enterobacter aerogenes) y durante 48 h a 37 °C (Enterecoccus faecalis) para realizar el conteo de células viables. Todas las pruebas se realizaron por duplicado, se seleccionaron las placas para su recue¡nto conforme a las recomendaciones de la American Public Health y se siguieron las pautas recomendadas para el cálculo de las UFC mL-1 [19].
Caracterización de las MNPs de Fe3O4 y del nanocompuesto de Fe3O4/Ag
La caracterización con espectroscopia infrarroja con Transformada de Fourier (FTIR) se realizó en un espectrofotómetro IRPrestige-21 Shimadzu en un rango de 400-4000 cm-1. La fase cristalina de las nanopartículas de Fe3O4 y Ag se identificaron por difracción de rayos X (DRX) mediante un difractómetro D8-FOCUS BRUKER con radiación Ka1-Cu (l = 0,15406 nm) a 40 kV y 40 mA. Para el análisis espectroscópico de Mössbauer, se usó un espectrómetro convencional en el modo de transmisión con una fuente de 57Co en matriz de rodio con una actividad de aproximadamente 12 mCi. Los espectros se acumularon a una velocidad de 11.017 ms-1 en 1024 canales usando señal sinusoidal. Las imágenes de microscopía electrónica de barrido (SEM) se obtuvieron con un FEG-SEM Zeiss Supra 40 y el tamaño de partícula se determinó usando el programa ImageJ.
Resultados y discusión
La Figura 1 muestra el espectro FTIR de las MNPs Fe3O4 y del nanocompuesto de Fe3O4/Ag. La banda de absorción fuerte alrededor de 578 cm-1 es debido al modo vibracional de estiramiento del Fe-O tetraédrico y la banda débil de menor intensidad alrededor de 450 cm-1 corresponde a un modo vibracional de estiramiento de Fe-O octaédrico [9]. A partir de esta caracterización, se evidencia la formación de la magnetita (Fe2+ohFe3+ohFe3+thO4) con la presencia de los enlaces Fe-O en sitios tetraédricos y octaédricos. La presencia de estas bandas no cambia en el nanocompuesto, indicando que se mantiene la estructura de la magnetita y que las nanopartículas de Ag solo la recubren.

Los patrones DRX de MNPs de Fe3O4 y del nanocompuesto Fe3O4/Ag se pueden observar en la Figura 2. La presencia de picos de difracción (Figura 2a) a 2q=18,3; 30,1; 35,5; 43,1; 53,3; 56,9; 62,5 y 74,3 corresponden a los planos (111), (220), (311), (400), (422), (511), (440) y (533), respectivamente (JCPDS No. 19-0629), lo cual indica la presencia de Fe3O4 con una celda unitaria cúbica centrada en las caras y una estructura tipo espinela.
En la Figura 2b, los picos de difracción de las NPs-Ag en el nanocompuesto de Fe3O4/Ag, se presentan en los ángulos 2q=38,2°; 44,2°; 64,5° y 77,5°, estos fueron comparados con la cartilla JCPDS No. 04-0783 asignándose los planos (111), (200), (220) y (311), respectivamente, que corresponden a una fase cúbica centrada en las caras.
El patrón de intensidad de los picos de difracción para las MNPs de Fe3O4 en la Figura 2a no difiere del registrado en la Figura 2b, lo cual demuestra que el proceso de síntesis no afectó a la forma cristalina de Fe3O4 y que la Ag recubre a las MNPs de Fe3O4. Las nanopartículas de Fe3O4 se pueden oxidar a Fe2O3, por lo cual, es necesario analizar las nanopartículas con otras técnicas de caracterización que permitan verificar si se produce la oxidación.

El diámetro medio de cristalito de la MNPs de Fe3O4 y del nanocompuesto se calculó a partir del pico más representativo, de intensidad máxima, con base en la ecuación de Debye y Scherrer, Ec. (1):
EC. (1)Donde, λ=Longitud de onda de la emisión CuKα=1,5406 Å, β=Ancho de pico (2θ) a la altura media, θ=Ángulo de intensidad máxima.
El diámetro del cristalito para las MNPs de Fe3O4 fue de 11 nm, plano (311). Para el caso de las MNPs de Fe3O4 en el nanocompuesto, el diámetro fue de 12 nm y para las NPs de Ag fue de 18 nm, usando el plano (111). Se evidenció que el tamaño de cristalito de las NPs de Ag es mayor que las MNPs de Fe3O4.
Los espectros Mössbauer correspondientes a las muestras de MNPs de Fe3O4 y del nanocompuesto de Fe3O4/Ag se describen en la Figura 3. Estos espectros se realizaron para estudiar la pureza de la fase del óxido de hierro y así determinar sus propiedades magnéticas. Ambos gráficos muestran un ajuste de distribución: tres sextetos asociados con sitios magnéticos y un doblete asociado a un posible estado superparamagnético, un comportamiento que difiere de un espectro de una magnetita estequiométrica. La distribución representa campos magnéticos desordenados con un campo magnético promedio de 40,15 T asociado con el efecto superficial de las partículas. Asi mismo, los sextetos corresponden a los sitios octaédricos de Fe2+ y los sitios octaédricos y tetraédricos del Fe3+ en la magnetita, por otra parte, el doblete está relacionado con los cationes Fe2+. En la magnetita existe el mismo número de iones Fe3+ en los sitios Oh y Td, que se compensan entre sí y su magnetización resultante surge únicamente de los iones Fe2+ no compensados en sitios Oh [20].
La magnetita no estequiométrica tiene la fórmula general Fe3-xO4 con 0 <x <0,33. Asumiendo que las vacantes (#) solo se encuentran en los sitios octaédricos de la estructura, la fórmula se puede escribir como [20]:

La estequiometría se puede convertir mediante la siguiente relación, Ec. (2):
(2)El salto rápido de electrones entre el OhFe3+ y OhFe2+, el cual se conoce como un fenómeno de la magnetita, resulta en átomos de OhFe con estado de valencia promedio de 2,5+ por una cantidad igual de Fe2+ y Fe3+ octaédrico, dando la siguiente fórmula [21]:

El espectro tiene tres sextetos: uno para Fe2.5+ y dos para Fe3+. A partir de los espectros de magnetita a 298 K, es posible estimar la estequiometria comparando las áreas relativas de los espectros correspondientes al OhFe3+, TdFe3+ y OhFe2.5+ usando la Ec. (3) [20]:
(3)En la evaluación para determinar la estequiometría de las MNPs de magnetita, siguiendo el modelo planteado, es posible diferenciar a los sitios TdFe3+, OhFe3+ y OhFe2+. A partir de los datos de área relativa del espectro de las MNPs de magnetita (Figura 3a) se obtiene un valor de X=0,24 y x=0,280. El valor de X=0,24 indica que las MNPs de magnetita tienen 80.6% de Fe3+ y 19.4% de Fe2+, indicando más especies de Fe3+ que Fe2+ en la red cristalina. Esta relación es menor que la relación estequiométrica de la magnetita pura X=0,5, evidenciando esto que posiblemente la magnetita este parcialmente oxidada. Las MNPs de magnetita tendrían la siguiente fórmula:

La estequiometría de las MNPs de magnetita en el nanocompuesto resulta en un valor de X=0,22 y x=0,282; estos valores indican que las MNPs de magnetita en el nanocompuesto tienen 82% Fe3+ y 18% Fe2+, mostrando más especies de Fe3+ que Fe2+ en la red y en mayor proporción que la muestra de magnetita sola que tiene X=0,24. Las MNPs de magnetita en el nanocompuesto tendrían la siguiente fórmula:

Los resultados indican que existe un menor porcentaje de Fe2+ en las MNPs de magnetita y en el nanocompuesto que en la magnetita pura (Tabla 1), ya que se trata de una magnetita no estequiométrica. A su vez, la magnetización en el nanocompuesto (%Fe2+: 18%) disminuye, debido, probablemente, a la presencia de las nanopartículas de plata. Por tanto, el nanocompuesto presenta una actividad antibacteriana con una ligera disminución de la magnetización de la magnetita.


En la Figura 4, se observa el espectro Raman de las MNPs de Fe3O4 y del nanocompuesto Fe3O4/Ag con señales características de magnetita [22] y otras señales a 355 cm-1 y 722 cm-1 de maghemita [22]. Estas últimas presentan mayor intensidad en el espectro del nanocompuesto, indicando un mayor porcentaje de oxidación con respecto a las MNPs de Fe3O4.

El diámetro promedio de partícula aproximado, utilizando el microscopio electrónico de barrido (SEM) para las MNPs de Fe3O4, fue de 10 nm (Figura 5a) y, para el nanocompuesto de Fe3O4/Ag, de, aproximadamente, 28 nm (Figura 5b). La imagen de las MNPs indica que están formadas por partículas aglomeradas y en la imagen del nanocompuesto se evidencian partículas más grandes recubriendo a las MNPs aglomeradas. Las partículas de alrededor de 28 nm que recubren a las MNPs se refieren a las NPs de Ag. Se realizó EDX para identificar la composición de las muestras en las MNPs de Fe3O4 y del nanocompuesto.
La Figura 6a muestra el espectro EDX, el cual presenta hierro Fe 2p. La presencia de Ca y K está relacionada probablemente con la contaminación de la muestra. El análisis EDX muestra tres picos de Fe y un pico de O, lo que confirma la formación de óxido de hierro como magnetita de acuerdo con su porcentaje de masa. La relación molar de Fe/O es igual a 0,72, un valor muy cercano al dato teórico, 0.75. En la Figura 6b, el nanocompuesto está compuesto de elementos O, Fe y Ag, lo cual confirma la identidad del nanocompuesto Fe3O4/Ag. El espectro EDX presenta hierro Fe 2p y Ag 3d. El pico de absorción óptica se observó a aproximadamente 3 keV, lo cual es típico para la absorción de nanopartículas de plata metálica, debido a la resonancia de plasmón superficial [23]. El contenido de plata en toda la muestra del nanocompuesto fue de 12 % en masa respecto a la magnetita.

Análisis de la actividad antibacteriana del nanocompuesto de magnetita/plata
Las placas incubadas de los controles y del tratamiento con el nanocompuesto, después de la incubación de Enterobacter aerogenes y Enterococcus faecalis, se muestran en la Figura 6. Para el caso de Enterobacter aerogenes, se obtuvo un promedio final de 95 x 106 UFC mL-1 para ambos controles y para la bacteria Enterococcus faecalis, el promedio resultó de 95 x 106 UFC mL-1 para el control 1 y 22 x 107 UFC mL-1 para el control 2. Estos valores se asemejan al valor inicial de las bacterias de 108 UFC mL-1. Para el tratamiento de 1 mL de cada solución bacteriana con 3 mg del nanocompuesto, se evidenció una colonia crecida para la bacteria Enterobacter aerogenes y dos colonias crecidas para la bacteria Enterococcus faecalis. Por esta razón, se realizó el tratamiento con 5 mg del nanocompuesto, donde no se evidenciaron colonias crecidas, indicando una eficiencia del 100%, el cual puede ser comparable con Theamdee et al. [6], donde su eficiencia frente a la Escherichia coli K12 es 100%, usando 10 mg de su nanocompuesto magnético.
Estos resultados fueron favorables, sobre todo para el caso de la bacteria Enterococcus faecalis, la cual es una bacteria del Filo Firmicutes Gram positivo que posee una pared celular muy gruesa que le podría otorgar una mayor resistencia estructural en comparación a la bacteria Enterobacter aerogenes (con una membrana externa y una pared celular más delgada) [24]. La actividad antimicrobiana de las nanopartículas de plata también es de gran interés, ya que parece ser independiente de la cepa de bacterias [25]. Li et al. [26] señalan tres posibles mecanismos antibacterianos de nanopartículas de plata: (1) La adhesión de las nanopartículas a la superficie de bacterias alteran la permeabilidad de la membrana. (2) Las nanopartículas de plata que penetran en el interior de la célula bacteriana causan daños en el ADN. (3) La disolución de las nanopartículas de plata que liberan iones Ag+ pueden interactuar con las proteínas que contienen azufre en la pared celular bacteriana.
Conclusiones
La investigación demostró la síntesis del nanocompuesto de Fe3O4/Ag, donde las nanopartículas de Ag se obtuvieron a partir de la reducción in situ con glucosa, recubriendo las MNPs de magnetita, las cuales presentaron forma esférica con un tamaño promedio de 18 nm. De acuerdo al estudio cristalográfico por DRX, se observó la presencia de Fe3O4 con una celda unitaria cúbica centrada en las caras y estructura tipo espinela en las MNPs de Fe3O4, la cual no varió con la presencia de NPs de Ag en el nanocompuesto. El plano preferencial para las NPs de plata fue el (111), evidenciando su presencia en el nanocompuesto. Según la espectroscopía Mössbauer, las MNPs de magnetita solas y en el nanocompuesto presentan un porcentaje de Fe3+ de aproximadamente 80% y 82% respectivamente, contrastadas con el valor teórico de 66,6 %, corroborando así que la magnetita sintetizada tiene una estructura no estequiométrica y menos magnética que la teórica. Por otra parte, las bandas de maghemita presentes en la espectroscopia Raman, junto con las de magnetita, confirman lo analizado por Mössbauer.
La ventaja del nanocompuesto es la fácil respuesta a un campo magnético aplicado y su eficiencia antibacteriana frente a las bacterias Enterobacter aerogenes y Enterococcus faecalis, la cual fue de 100% (108 bacterias/nanocompuesto de 5 mg) con un tratamiento de 50 min e incubación a 37 °C. Finalmente, estos resultados indican que el nanocompuesto antibacteriano puede usarse potencialmente en la desinfección microbiológica del agua para la inhibición del crecimiento bacteriano.
Agradecimientos
Los autores agradecen a la Universidad Nacional de Ingeniería (UNI) y al Laboratorio de Microbiología Molecular y Biotecnología de la Facultad de Biología de la UNMSM por las instalaciones de los laboratorios y los equipos. Los autores también agradecen al Dr. José Carlos Díaz Rosado por las facilidades del análisis de Dispersión de energía de rayos X y al Dr. Adolfo La Rosa Toro por el análisis Raman en la Facultad de Ciencias-UNI.
Referencias
[1] H. Xia et al., “Synthesis and characterization of Fe3O4@C@Ag nanocomposites and their antibacterial performance,” Appl. Surf. Sci., vol. 257, n° 22, pp. 9397–9402, 2011. DOI: https://doi.org/10.1016/j.apsusc.2011.06.016
[2] S. Shrivastava, T. Bera, A. Roy, G. Singh, P. Ramachandrarao, and D. Dash, “Characterization of enhanced antibacterial effects of novel silver nanoparticles,” Nanotechnology, vol. 18, n° 22, p. 225103, 2007. DOI: https://doi.org/10.1088/0957-4484/18/22/225103
[3] W. Fang et al., “One-pot synthesis of porous Fe3O4 shell/silver core nanocomposites used as recyclable magnetic antibacterial agents,” J. Magn. Magn. Mater., vol. 357, pp. 1–6, 2014. DOI: https://doi.org/10.1016/j.jmmm.2014.01.024
[4] 4th Ed. Geneva World Health Organization, WHO. Guidelines for Drinking-Water Quality. 2011. [Online]. Available: http://apps.who.int/iris/bitstream/handle/10665/44584/9789241548151_eng.pdf;jsessionid=4AF69D7291A533EFA13B0AC98EBEAAE0?sequence=1
[5] M. K. Joshi et al., “In-situ deposition of silver−iron oxide nanoparticles on the surface of fly ash for water purification,” J. Colloid Interface Sci., vol. 453, pp. 159–168, 2015. DOI: http://doi.org/10.1016/j.jcis.2015.04.044
[6] P. Theamdee, B. Rutnakornpituk, U. Wichai, M. Nakkuntod, and M. Rutnakornpituk, “Recyclable silver–magnetite nanocomposite for antibacterial application,” J. Ind. Eng. Chem., vol. 29, pp. 63–70, 2015. DOI: http://doi.org/10.1016/j.jiec.2015.03.018
[7] M. . Vergés et al., “Uniform and water stable magnetite nanoparticles with diameters around the monodomain–multidomain limit,” J. Phys. D. Appl. Phys., vol. 41, n° 13, pp. 134003, 2008. DOI: http://doi.org/10.1088/0022-3727/41/13/134003
[8] O. Ivashchenko et al., “Synthesis and characterization of magnetite/silver/antibiotic nanocomposites for targeted antimicrobial therapy,” Mater. Sci. Eng. C, vol. 55, pp. 343–359, 2015. DOI: http://doi.org/10.1016/j.msec.2015.05.023
[9] A. Amarjargal, L. D. Tijing, I.-T. Im, and C. S. Kim, “Simultaneous preparation of Ag/Fe3O4 core–shell nanocomposites with enhanced magnetic moment and strong antibacterial and catalytic properties,” Chem. Eng. J., vol. 226, pp. 243–254, 2013. DOI:
[10] R. Prucek et al., “The targeted antibacterial and antifungal properties of magnetic nanocomposite of iron oxide and silver nanoparticles,” Biomaterials, vol. 32, no. 21, pp. 4704–4713, 2011. DOI: http://doi.org/10.1016/j.biomaterials.2011.03.039
[11] M. Mahmoudi and V. Serpooshan, “Silver-coated engineered magnetic nanoparticles are promising for the success in the fight against antibacterial resistance threat,” ACS Nano, vol. 6, n° 3, pp. 2656–2664, 2012. DOI: http://doi.org/10.1021/nn300042m
[12] C. Yong, X. Chen, Q. Xiang, Q. Li, and X. Xing, “Recyclable magnetite-silver heterodimer nanocomposites with durable antibacterial performance,” Bioact. Mater., vol. 3, n°. 1, pp. 80–86, 2018. DOI: https://doi.org/10.1016/j.bioactmat.2017.05.008
[13] S. M. Ghaseminezhad and S. A. Shojaosadati, “Evaluation of the antibacterial activity of Ag/Fe3O4 nanocomposites synthesized using starch,” Carbohydr. Polym., vol. 144, pp. 454–463, 2016. DOI: https://doi.org/10.1016/j.carbpol.2016.03.007
[14] M. Allen, “La importancia para la salud pública de los indicadores bacterianos que se encuentran en el agua potable. Reunión sobre la calidad del agua potable. CEIPS.OPS.OMS. Lima, Perú,” 1996.
[15] V. R. Vergaray, G. Méndez, C.R. Morante, H.Y. Heredia, V.I. Béjar, “Enterococcus y Escherichia coli como indicadores de contaminación fecal en playas costeras de Lima,” Rev. Inst.Investig.F.G.M.M.G, vol. 10, n° 20, pp. 6–82, 2007. [En línea]. Disponible en: http://sisbib.unmsm.edu.pe/BibVirtualData/publicaciones/geologia/vol10_n20/a11.pdf
[16] V. J. Cabelli, A. P. Dufour, M. A. Levin, L. J. McCabe, and P. W. Hberman, “The impact of pollution on marine bathing beaches. An epidemiological study,” Linnology Oceanogr. Spec. Symp, vol. 2, pp. 424–432, 1975.
[17] H. Wang, X. Qiao, J. Chen, X. Wang, and S. Ding, “Mechanisms of PVP in the preparation of silver nanoparticles,” Materials Chemistry and Physics, vol. 94, n°. 2–3. pp. 449–453, 2005. DOI: https://doi.org/10.1016/j.matchemphys.2005.05.005
[18] S. Banerjee et al., “A regular rippled pattern formed by the molecular self-organization of polyvinylpyrrolidone encapsulated Ag nanoparticles: A high transmissive coating for efficiency enhancement of c-Si solar cells,” RSC Adv., 2015. DOI: https://doi.org/10.1039/C4RA11684D
[19] APHA/AWWA/WEF (American Public Health Association/ American Water Works Association/ Water Environment Federation)., “Standard Methods for the examination of water and wastewater (22nd ed).,” Stand. Methods, pp. 1496, 2012.
[20] C. A. Gorski and M. M. Scherer, “Determination of nanoparticulate magnetite stoichiometry by Mössbauer spectroscopy, acidic dissolution, and powder X-ray diffraction: A critical review,” Am. Mineral., vol. 95, n°. 7, pp. 1017–1026, 2010. DOI: https://doi.org/10.2138/am.2010.3435
[21] C. A. Gorski, “Redox behavior of magnetite in the environment : moving towards a semiconductor model,” 2009.
[22] K. Murugappan, D. S. Silvester, D. Chaudhary, and D. W. M. Arrigan, “Electrochemical characterization of an oleyl-coated magnetite nanoparticle-modified electrode,” ChemElectroChem, vol. 1, n° 7, pp. 1211–1218, 2014. DOI: https://doi.org/10.1002/celc.201402012
[23] S.-K. Manivasagan, P.Venkatesan, J. Senthilkumar, K. Sivakumar,K. Kim, “Biosynthesis, antimicrobial and cytotoxic effect of silver nanoparticles using a novel Nocardiopsis sp. MBRC-1,” BioMed. Res. Int., pp. 1–9, 2013. DOI: http://dx.doi.org/10.1155/2013/287638
[24] M. Valls and V. De Lorenzo, “Exploiting the genetic and biochemical capacities of bacteria for the remediation of heavy metal pollution,” FEMS Microbiol. Rev., vol. 26, n° 4, pp. 327–338, 2002. DOI: https://doi.org/10.1111/j.1574-6976.2002.tb00618.x
[25] B. Reidy, A. Haase, A. Luch, K. A. Dawson, and I. Lynch, “Mechanisms of silver nanoparticle release, transformation and toxicity: A critical review of current knowledge and recommendations for future studies and applications,” Materials (Basel)., vol. 6, n° 6, pp. 2295-2350, 2013. DOI: https://doi.org/10.3390/ma6062295
[26] Q. Li et al., “Antimicrobial nanomaterials for water disinfection and microbial control: Potential applications and implications,” Water Research. vol. 42, n° 18, pp. 4591-4602, 2008. DOI: https://doi.org/10.16/j.watres.2008.08.015